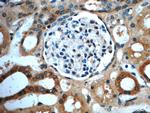
GNRHR2 Antibody in Immunohistochemistry (Paraffin) (IHC (P))

Search
Proteintech
GNRHR2 Polyclonal Antibody
{{$productOrderCtrl.translations['antibody.pdp.commerceCard.promotion.promotions']}}
{{$productOrderCtrl.translations['antibody.pdp.commerceCard.promotion.viewpromo']}}
{{$productOrderCtrl.translations['antibody.pdp.commerceCard.promotion.promocode']}}: {{promo.promoCode}} {{promo.promoTitle}} {{promo.promoDescription}}. {{$productOrderCtrl.translations['antibody.pdp.commerceCard.promotion.learnmore']}}
产品信息
20728-1-AP
种属反应
宿主/亚型
分类
类型
抗原
偶联物
形式
浓度
规格
纯化类型
保存液
内含物
保存条件
运输条件
靶标信息
In non-hominoid primates and non-mammalian vertebrates, the gonadotropin releasing hormone 2 receptor gene (GnRHR2) encodes a seven-transmembrane G-protein coupled receptor. However, in human, the corresponding reading frame contains a premature stop codon, which has been suggested to encode a selenocysteine residue, but there is no solid evidence for selenocysteine incorporation. It appears that the human GnRHR2 transcription occurs but the gene does not likely produce a functional multi-transmembrane protein. A non-transcribed pseudogene of GnRHR2 is located on chromosome 14. Multiple alternatively spliced transcript variants have been found for this gene.
仅用于科研。不用于诊断过程。未经明确授权不得转售。
篇参考文献 (0)
生物信息学
基因别名: GnRH-II-R; GNRHR2P
Entrez Gene ID: (Human) 114814